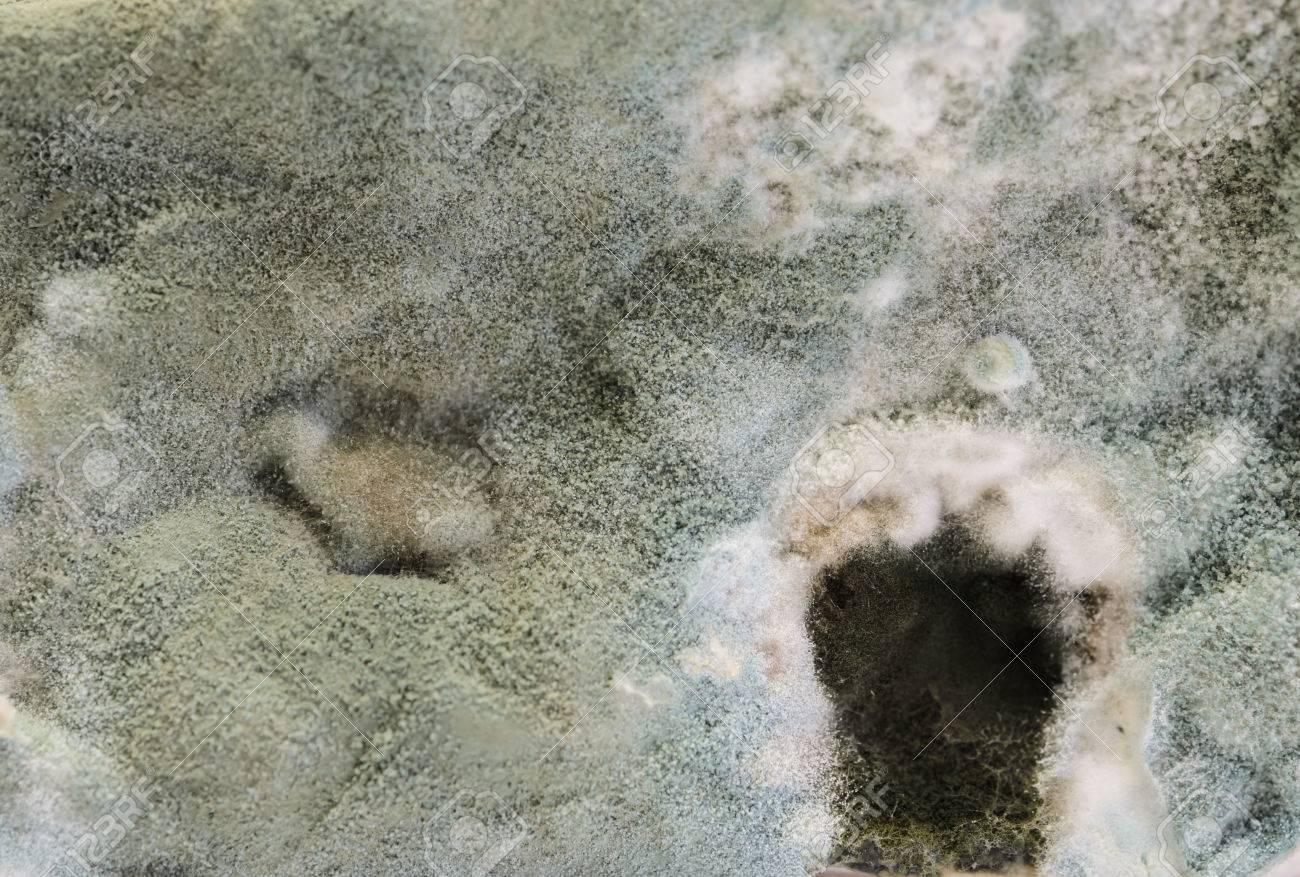
etiam-dictum-ipsum-a-felis

Download
Close
Автор:
id:
Ключевые слова:
background, bacteria, bacterium, bad, biology, bread, cake, closeup, cover, danger, decay, dirty, food, fungal, fungi, fungus, gray, green, growth, harmful, illness, infected, macro, microbiology, microorganism, mildew, moisturce, mold, moldy, mould, nature, old, poisoning, poisonous, rotten, slice, sliced, spoil, spore, texture, toxic, ugliness, unhealthy, unhygienic, water, white,





